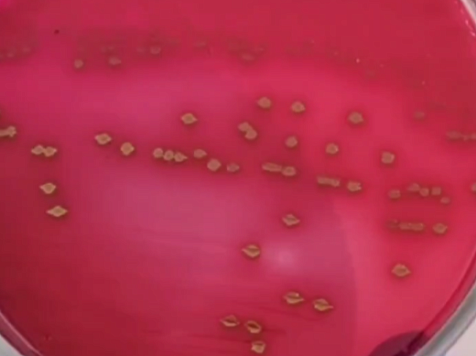

В Красноярске специалисты РПН провели эксперимент с немытыми алюминиевыми банками и показали, какие бактерии на них обитают.
— Мы решили наглядно показать, какая опасность может поджидать на крышке немытой банки. Для этого в лабораторию ФБУЗ «Центр гигиены и эпидемиологии в Красноярском крае» мы принесли на исследование алюминиевые банки.
С банок газировки, мытой и немытой, собрали материал и сделали посев. Чашки Петри убрали в термостат. Спустя время исследователи посмотрели на результаты и увидели, что основную часть выявленных микробов составили бактерии группы кишечной палочки, а также другие условно патогенные микроорганизмы.
Ранее крупная сеть доставки суши привезла красноярке роллы с червем. Некоторые из роллов неприятно пахли, а зелень на продукте была вялой